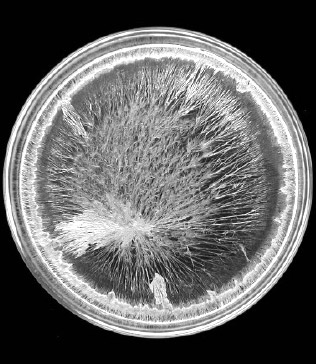

WASSERFORSCHUNG?

Viktor Schauberger – der Urvater der modernen Wasserforschung – wurde 1885 in Oberösterreich geboren und absolvierte zunächst eine Ausbildung zum Förster. Durch Naturbeobachtungen gewann er Ansichten, die ihn das naturwissenschaftliche Weltbild in Frage stellen ließen. Er glaubte, der Natur liege ein bisher nicht bekanntes Bewegungsprinzip zugrunde, welches er „Implosion“ nannte. Basierend auf dieser Erkenntnis baute er Wasseraufbereitungsanlagen, die ohne jeden Zusatz von Chemikalien oder Zufuhr von Strom trübes Schmutzwasser in kristallklares Wasser verwandelten. Erst nach Viktor Schaubergers Tod wurde dieses Prinzip zur Entwicklung moderner Wasserwirbler, wie sie heute tausendfach eingesetzt werden, genutzt.

Ende der 1970er Jahre begann Johann Grander sich intensiv mit natürlichem Magnetismus und Wasser zu beschäftigen. Am Ende seiner jahrelangen Experimentier- und Forschungstätigkeit kam er zu der Erkenntnis, dass Wasser die Fähigkeit zur Informationsübertragung besitzt. Aus diesem Wissen heraus entwickelte er Wasserbelebungsgeräte, die dem heute durch verschiedenste Einflüsse belasteten Wasser seine verloren gegangenen Eigenschaften – wie Selbstreinigungs- und Widerstandskraft – zurückgeben können.

Der Japaner Masuru Emoto studierte zunächst Politikwissenschaften und beschäftigte sich seit Anfang der 1990er Jahre mit dem physio-chemischen Phänomen der Zusammenballung von Wassermolekülen. Er vertrat die Auffassung, dass Wasser die Einflüsse von Gedanken und Gefühlen aufnehmen und speichern kann. Emoto fotografierte Wasser während es gefriert und beurteite anhand von ästhetisch-morphologischen Kriterien den entstehenden Eiskristall. So stellte er einen gewiossen Zusammenhang zwischen dem Aussehen des Eiskristalls und der Qualität bzw. dem Zustand des Wassers her. Seinen Hypothesen zufolge formt mit positiven Botschaften beschriftetes Wasser stets vollkommene Eiskristalle, während Wasser mit negativen Botschaften unvollkommene Kristallformen ausbildet.

Prof. Dr. Bernd-Helmut Kröplin studierte Bauingenieurwesen an der TU Braunschweig und leitete unter andererm von 1988 bis 2010 das Institut für Statik und Dynamik der Luft- und Raumfahrtkonstruktionen der Universität Stuttgart. Durch sein Interesse, ob und wie geringe elektromagnetische Strahlung auf den menschlichen Organismus wirken und wie sie sichtbar gemacht werden kann, begann die Wasserforschung und Kröplin trat durch erste Schriften zu dem von ihm postulierten „Gedächtnis des Wassers“ in Erscheinung. Es folgte die vielbeachtete Wanderausstellung „Welt im Tropfen“ und die Veröffentlichung eines ersten Buches zu diesem Thema. Er trat mehrfach im Fernsehen und im Mai 2012 auch auf dem Deutschen Homöopatie-Kongress auf. Die Kenntnisse zur Informationsspeicherung im Wasser sind Grundlage für viele Produkte zur Herstellung von belebtem Wasser.
dein Vater niemals war, so dass deine
Kinder die Chance haben das
zu werden was Du gerne sein möchtest!
HAT WASSER EIN GEDÄCHTNIS
Einen beeindruckenden, wissenschaftlichen Nachweis für die unglaublichen Eigenschaften von Wasser liefert der Japaner Masaru Emoto. Er dokumentiert mit Wasserkristallbildern den energetischen Zustand von Wasser. In zehntausenden Versuchen hat Dr. Masaru Emoto herausgefunden, dass Wasser nicht nur gute und schlechte Informationen, Musik und Worte, sondern auch Gefühle und Bewusstsein speichert. Ist es sehr hochwertig, zeigt sich in der Regel ein schön geformter, meist sechseckiger Kristall, ähnlich wie bei Schneeflocken. Beeinträchtigtes Wasser ist hingegen nicht mehr in der Lage, einen vergleichbaren Kristall auszubilden. Wasser ist in der Lage, Musik, Worte und Gefühle zu speichern.
Mozarts Sinfonie Nr. 40: Sanfte Musik, die zu Herzen geht. Sieh, wie sie in die Mitte des Kristalls reicht.
Heavy Metal: Laute, dröhnende Musik mit Texten, die von Zorn und Wut handeln. Haben diese Worte den Kristall in tausend Stücke zerbrochen?
WASSER HAT VIELE GESICHTER
Was wäre, wenn...
• das Wasser ein Gedächtnis hätte?
Dann wüsste das Meer von der Quelle und die Quelle vom Meer?
• die Wasser miteinander sprächen, es eine Informationsübertragung im Wasser gäbe?
• Gedankenformen abgebildet werden könnten?
• das Wasser ein Spiegel wäre?

Bodensee

Rheinwasser
Seit mehr als fünfzehn Jahren forschen Prof. Dr. Bernd-Helmut Kröplin
und sein Team an diesem Thema. Die Aufnahmen unter dem Dunkelfeldmikroskop
geben erstaunliche Einblicke in ein Medium, das uns
tagtäglich umgibt und das wir zu kennen glauben.
Wasser ist nicht nur Lösungsmittel für Mineralien, Enzyme und
Vitamine, sondern scheint auch Informationsträger innerhalb der
Zelle und zwischen den Zellen zu sein. Es „merkt sich“, was mit ihm
passiert ist.
WIRKUNG DES ENERAKTIV

In den Proben ohne Eneraktiv® wurden Bereiche mit koagulierten (großen zusammenhängenden) und mit einzelnen Kristallen festgestellt, also keine brauchbare Härtestabilisierung. Kristalltypische Farbeffekte wurden nicht beobachtet.

Bei den Proben des mit dem Eneraktiv® behandelten Wassers bilden sich kaum noch koagulierte Kristallformen. Sie sind kleinen, runden, isolierten Einzelkristalliten gewichen, so dass man von einer guten Härtestabilisierung sprechen kann.

In den Proben ohne Eneraktiv® wurden Bereiche mit koagulierten (großen zusammenhängenden) und mit einzelnen Kristallen festgestellt, also keine brauchbare Härtestabilisierung. Kristalltypische Farbeffekte wurden nicht beobachtet.

Bei den Proben des mit dem Eneraktiv® behandelten Wassers bilden sich kaum noch koagulierte Kristallformen. Sie sind kleinen, runden, isolierten Einzelkristalliten gewichen, so dass man von einer guten Härtestabilisierung sprechen kann.
Biologische Wertigkeit (Dr. E. Langescheidt, Mönchengladbach)
4-prozentige Ascorbinsäurelösung nach 24 Stunden in abgeschirmter Umgebung: ohne den Eneraktiv sind Kristallstrukturen kaum fest feststellbar. Auch die für Kristalle typischen Interferenzfarben sind nicht erkennbar.

Im Gegensatz dazu bilden sich in der durch den Eneraktiv informierten Lösung ideal augebildete (einachsige) Kristalle mit einem klaren, punktförmigen Zentrum, von dem radiale Strahlen abgehen. Ebenso sieht man ein Polarisationskreuz. Die kristalltypischen Interferenzfarben sprechen für eine ideal zusammenhängende Kristallstruktur
Ascorbinsäureuntersuchung (Dr. E. Langescheidt, Mönchengladbach)

Die Kristallisationsmethode ist ein wichtiger Parameter für die Bioverfügbarkeit von Mineralien in Speisen.

Je ausgeprägter und formtypischer die Kristalle sind, desto höher ist deren Wertigkeit. Mit dem Eneraktiv wird die Intensität von mit Wasser zubereiteten Speisen undGetränken deutlich verbessert.
Die positive Wirkung ist offensichtlich.
Wissenschaftliche Schlussfolgerung: „Auf Grund der Versuchsergebnisse durch Dr. E. Langenscheidt wird bestätigt, dass der Eneraktiv® auf die Struktur bzw. Kristallisationsverhältnisse der im Wasser gelösten Substanzen (Mineralien) vitalisierend wirkt.“ Es entstehen Quellwasserstrukturen!
Alle Untersuchungsergebnisse liegen Bela Aqua im Original vor.
Wir sind dazu verpflichtet, Sie darauf aufmerksam zu machen, dass die Wirkung des Eneraktiv® nach naturwissenschaftlichen Kriterien nicht messbar ist. Alternative Messverfahren, die eine Wirkung belegen könnten, werden momentan wissenschaftlich noch nicht anerkannt. Die genannten Eigenschaften des Eneraktiv® beruhen zwar auf solchen, aber auch im Besonderen auf Erfahrungen, die im praktischen Umgang mit ihm gemacht wurden.
